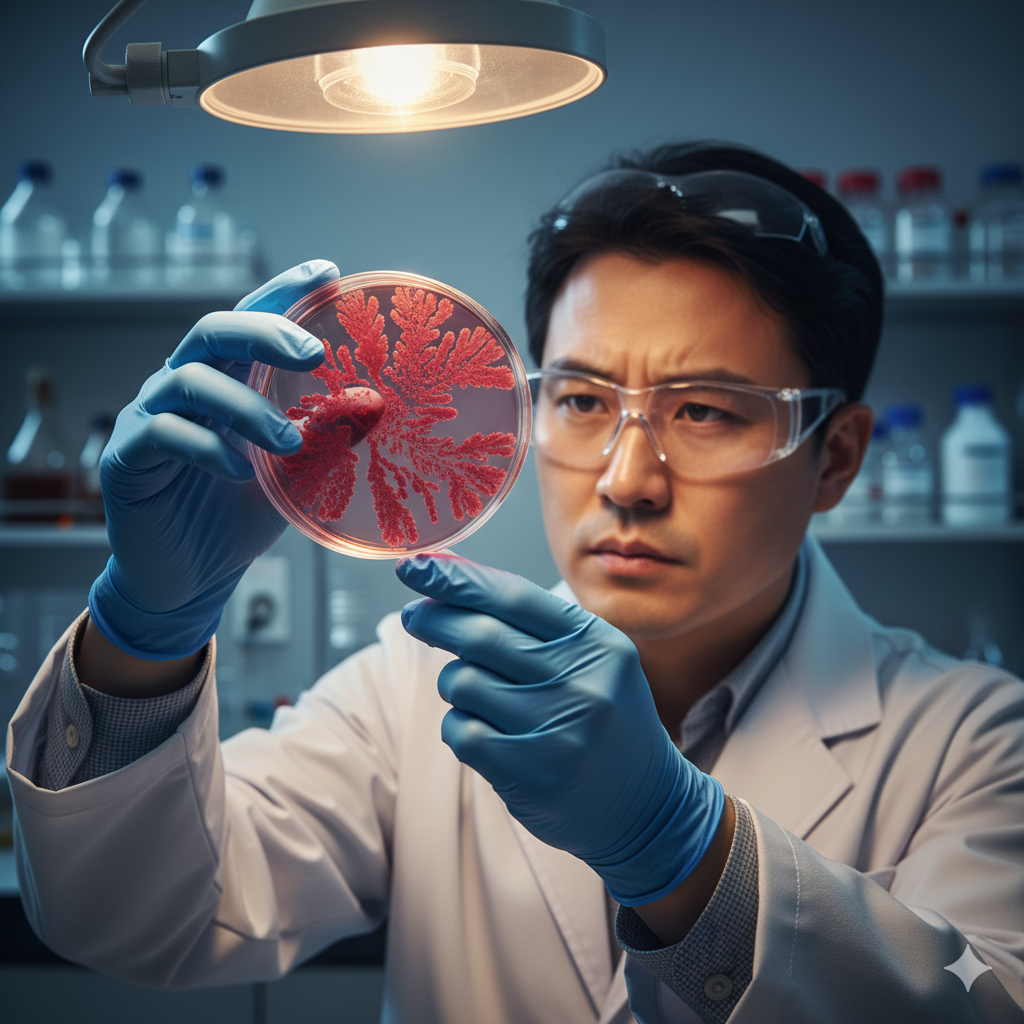

에이비엘바이오 시총 11조, 알테오젠 시총 27조.
둘 다 플랫폼 기술로 글로벌 빅파마와 조 단위 계약을 체결한 K-바이오의 대표 주자입니다.
그런데 뭐가 다르고, 2026년 누가 더 유리할까요?
지금 5분이면 두 회사의 핵심 기술부터 수익 구조, 투자 포인트까지 한눈에 비교해 드립니다.
목차
- 한눈에 보는 에이비엘바이오 vs 알테오젠
- 핵심 플랫폼 기술 비교
- 기술이전 계약 및 파트너사 비교
- 2026년 수익 구조와 모멘텀
- 투자 관점에서 누구를 선택할까?
1. 한눈에 보는 에이비엘바이오 vs 알테오젠
두 회사 모두 '신약' 자체가 아닌 '플랫폼 기술'로 승부합니다. 플랫폼 기술은 반환 위험이 낮고, 여러 약물에 적용 가능해 수익이 누적됩니다.
[기본 정보 비교]
에이비엘바이오
- 시가총액: 약 11조 원
- 핵심 기술: 이중항체, BBB셔틀(그랩바디-B)
- 주요 적용 분야: 퇴행성 뇌질환, 항암제
- 상장 시장: 코스닥
- 2025년 주가 상승률: +572%
알테오젠
- 시가총액: 약 27조 원
- 핵심 기술: 피하주사 제형 변환(ALT-B4)
- 주요 적용 분야: 면역항암제, ADC, 바이오시밀러
- 상장 시장: 코스닥 → 2026년 코스피 이전 예정
- 2025년 주가 상승률: +55%
에이비엘바이오는 2025년 한 해 동안 주가가 6배 이상 급등하며 폭발적 성장을 보였습니다. 알테오젠은 이미 대형주 반열에 올라 안정적인 상승세를 유지 중입니다.


2. 핵심 플랫폼 기술 비교
두 회사의 기술은 완전히 다른 영역을 공략합니다.
에이비엘바이오: 그랩바디-B (BBB셔틀)
뇌는 혈뇌장벽(BBB)이라는 방어막이 있어 약물이 쉽게 들어가지 못합니다. 알츠하이머, 파킨슨병 등 뇌질환 치료가 어려운 이유입니다.
에이비엘바이오의 그랩바디-B는 이 장벽을 뚫고 약물을 뇌로 전달하는 '셔틀' 기술입니다.
[그랩바디-B 작용 원리]
- 뇌 내피세포 표면의 IGF1R(인슐린유사성장인자 수용체)을 표적
- 약물이 BBB를 통과해 뇌 조직에 도달
- 항체, siRNA, 소분자 약물 등 다양한 약물에 적용 가능
💡 쉽게 말해, 뇌로 가는 '택시 서비스'입니다. 다양한 약물을 태워 뇌까지 안전하게 배달합니다.
알테오젠: ALT-B4 (피하주사 제형 변환)
기존 바이오 항암제는 대부분 정맥주사(IV)로 투여됩니다. 병원에서 30분~1시간 동안 맞아야 합니다.
알테오젠의 ALT-B4는 정맥주사를 피하주사(SC)로 바꿔줍니다. 1~2분이면 끝납니다.
[ALT-B4 작용 원리]
- 히알루로니다제 효소가 피부 조직의 히알루론산을 분해
- 대용량 약물이 피하 조직으로 빠르게 흡수
- 환자 편의성 ↑, 의료비용 ↓, 특허 연장 가능
💡 쉽게 말해, '투약 방식의 업그레이드'입니다. 약 성분은 그대로인데 맞는 방식만 바꿔 편의성을 높입니다.
기술 차이 핵심 정리
[기술 비교 요약]
에이비엘바이오 그랩바디-B
- 해결하는 문제: 약물이 뇌에 도달하지 못함
- 적용 대상: 퇴행성 뇌질환 신약
- 시장 특성: 신규 시장 개척 (블루오션)
- 경쟁 강도: 낮음 (기술 진입장벽 높음)
- 특허 만료: 2043년 이후
알테오젠 ALT-B4
- 해결하는 문제: 정맥주사 불편함
- 적용 대상: 기존 블록버스터 약물
- 시장 특성: 기존 시장 확대 (레드오션 진입)
- 경쟁 강도: 할로자임과 경쟁
- 특허 만료: 2043년 (할로자임은 2027~2032년 만료)
📌 에이비엘바이오는 새로운 치료제 개발에 필수적인 기술, 알테오젠은 기존 약물의 가치 연장에 필수적인 기술입니다.

3. 기술이전 계약 및 파트너사 비교
두 회사 모두 누적 계약 규모 10조 원을 돌파했습니다.
에이비엘바이오 주요 기술이전
[에이비엘바이오 빅딜 현황]
GSK (2024년 4월)
- 계약 규모: 4.1조 원
- 적용 기술: 그랩바디-B
- 적용 분야: 퇴행성 뇌질환 치료제
일라이 릴리 (2024년 11월)
- 계약 규모: 3.8조 원 + 지분투자 220억 원
- 적용 기술: 그랩바디-B
- 적용 분야: 퇴행성 뇌질환 치료제
사노피 (2022년 1월)
- 계약 규모: 1.3조 원
- 적용 기술: 그랩바디-B
- 적용 약물: ABL301 (파킨슨병)
컴퍼스 테라퓨틱스 (2018년)
- 계약 규모: 510억 원
- 적용 약물: ABL001 (담도암)
- 현황: 2026년 FDA 승인 예상
알테오젠 주요 기술이전
[알테오젠 빅딜 현황]
MSD (2020년, 2024년 독점 변경)
- 누적 계약: 1.4조 원 + 로열티
- 적용 약물: 키트루다 SC
- 현황: 2025년 9월 FDA 승인, 판매 개시
아스트라제네카 (2025년 3월)
- 계약 규모: 1.9조 원
- 적용 기술: ALT-B4
- 적용 분야: 다수 항체 치료제
다이이찌산쿄 (2024년 11월)
- 적용 약물: 엔허투 SC (ADC 항암제)
- 현황: 2025년 9월 임상 1상 개시
GSK/테사로 (2026년 1월)
- 계약 규모: 4,200억 원
- 적용 약물: 젬퍼리(도스탈리맙) SC
산도즈 (2024년 7월)
- 적용 분야: 바이오시밀러 SC
파트너사 비교
[파트너사 특징 비교]
에이비엘바이오
- 글로벌 파트너: GSK, 릴리, 사노피
- 파트너 특징: 뇌질환 개발 선도 빅파마
- 계약 성격: 신약 공동개발
- 반환 리스크: 임상 실패 시 존재 (단, 플랫폼 계약이라 낮음)
알테오젠
- 글로벌 파트너: MSD, AZ, 다이이찌산쿄, GSK, 산도즈
- 파트너 특징: 블록버스터 보유 빅파마
- 계약 성격: 기존 약물 제형 변경
- 반환 리스크: 거의 없음 (이미 검증된 약물 대상)
⚠️ 알테오젠은 이미 상용화된 약물에 기술을 적용하므로 반환 위험이 거의 없습니다. 에이비엘바이오는 신약 개발 단계에 적용되지만, 플랫폼 기술 자체는 검증되어 반환 사례가 없습니다.

4. 2026년 수익 구조와 모멘텀
가장 큰 차이는 '로열티 시작 시점'입니다.
알테오젠: 2026년 로열티 본격화
알테오젠은 키트루다 SC가 2025년 9월 FDA 승인을 받고 판매를 시작했습니다.
[키트루다 로열티 전망]
- 키트루다 연 매출: 42조 원 (2024년 기준, 세계 1위)
- SC 제형 전환율: 30~40% (보수적) ~ 최대 90%
- 알테오젠 로열티율: 약 2~5%
- 예상 연간 로열티: 수천억~1조 원 이상
💡 2026년은 알테오젠에게 첫 대규모 로열티 유입 원년입니다. 매 분기 수천억 원의 현금이 들어옵니다.
[2026년 알테오젠 모멘텀]
- 키트루다 SC 로열티 본격화
- 유럽 키트루다 SC 승인 및 출시
- 코스피 이전 상장 (패시브 자금 유입)
- 추가 기술이전 계약 (10여 개 빅파마와 협의 중)
- 엔허투 SC 임상 1상 진행
에이비엘바이오: 2027년 로열티 시작 전망
에이비엘바이오는 아직 상용화된 약물이 없습니다. 하지만 ABL001 담도암 치료제가 2027년 FDA 승인을 받으면 첫 로열티가 시작됩니다.
[ABL001 FDA 승인 로드맵]
- 2026년 상반기: OS·PFS 최종 결과 발표
- 2026년 하반기: FDA BLA(허가신청서) 제출
- 2027년 상반기: FDA 승인 예상 (패스트트랙 6개월 심사)
[2026년 에이비엘바이오 모멘텀]
- ABL001 담도암 최종 결과 발표 (상반기)
- ABL111 위식도암 임상 1b상 추가 데이터
- 이중항체 ADC(ABL206, ABL209) 임상 1상 개시
- 그랩바디-B 추가 기술이전 가능성
- GSK·릴리 파이프라인 진행 상황
📌 에이비엘바이오는 2026년이 '임상 결과의 해', 알테오젠은 **'로열티의 해'**입니다.
수익 구조 비교
[수익 인식 비교]
알테오젠
- 현재 수익: 마일스톤 + 키트루다 로열티 시작
- 2026년 예상: 로열티 수천억 원 유입
- 수익 안정성: 높음 (이미 상용화)
- 2025년 3분기 누적 영업이익: 873억 원
에이비엘바이오
- 현재 수익: 마일스톤 중심
- 2026년 예상: 마일스톤 지속 (로열티는 2027년~)
- 수익 안정성: 임상 결과에 따라 변동
- 영업이익: 적자 (R&D 투자 단계)

5. 투자 관점에서 누구를 선택할까?
투자 성향에 따라 선택이 달라집니다.
알테오젠이 적합한 투자자
[알테오젠 강점]
- 즉시 현금 창출: 2026년부터 로열티 수천억 원
- 낮은 반환 리스크: 이미 검증된 약물에 적용
- 코스피 이전: 패시브 자금 유입 기대
- 특허 우위: 2043년까지 (경쟁사 할로자임은 2027~2032년 만료)
- 다양한 파트너: MSD, AZ, GSK 등 5개 빅파마
[알테오젠 리스크]
- 높은 밸류에이션 (시총 27조 원)
- 할로자임과 특허 분쟁 진행 중
- 로열티율(2~5%)이 시장 기대보다 낮을 수 있음
💡 "당장 실적이 나오는 안정적인 바이오주를 원한다" → 알테오젠
에이비엘바이오가 적합한 투자자
[에이비엘바이오 강점]
- 신규 시장 개척: BBB셔틀 기술의 독보적 위치
- 성장 잠재력: 퇴행성 뇌질환 시장 폭발적 성장 예상
- 빅파마 검증: GSK·릴리·사노피 3곳이 동시 선택
- 상대적 저평가: 시총 11조 원 (알테오젠의 40%)
- 다양한 임상 촉매: ABL001, ABL111, ADC 등
[에이비엘바이오 리스크]
- 아직 상용화 제품 없음 (로열티 2027년 이후)
- 사노피 ABL301 '우선순위 조정' 이슈
- 임상 실패 시 주가 변동성 큼
💡 "미래 성장성에 베팅하고 싶다" → 에이비엘바이오
핵심 비교 요약
[최종 비교표]
투자 안정성
- 알테오젠: ★★★★★ (로열티 확정)
- 에이비엘바이오: ★★★☆☆ (임상 결과 대기)
성장 잠재력
- 알테오젠: ★★★★☆ (시장 확대형)
- 에이비엘바이오: ★★★★★ (신규 시장 개척)
2026년 모멘텀
- 알테오젠: ★★★★★ (로열티 본격화)
- 에이비엘바이오: ★★★★☆ (임상 결과 발표)
밸류에이션 매력
- 알테오젠: ★★★☆☆ (고평가 논쟁)
- 에이비엘바이오: ★★★★☆ (상대적 저평가)
반환 리스크
- 알테오젠: ★★★★★ (거의 없음)
- 에이비엘바이오: ★★★★☆ (낮음)
마무리
지금까지 에이비엘바이오와 알테오젠을 비교 분석했습니다.
- 알테오젠: 2026년 키트루다 로열티 본격화, 안정적인 현금 창출 시작
- 에이비엘바이오: 2026년 담도암 임상 결과 발표, 성장 잠재력 입증 기회
- 두 회사 모두 플랫폼 기술로 반환 리스크가 낮고 누적 계약 10조 원 돌파
- 알테오젠은 '즉시 수익', 에이비엘바이오는 '미래 성장'에 강점
둘 중 하나만 고르기 어렵다면, 포트폴리오 분산도 전략입니다. K-바이오 플랫폼 기업 두 곳에 함께 투자하는 것도 방법입니다.
알아두면 좋은 정보:
에이비엘바이오 주가 전망 2026 | 시총 10조 바이오 대장주 분석
알테오젠 코스피 이전, 코스닥 바이오 대장주 경쟁 구도 총정리
에이비엘바이오 기술이전 비교 - 사노피 GSK 릴리 계약 구조 총정리 2026년
에이비엘바이오 릴리 기술이전 3.8조 계약 | 계약금 선급금 마일스톤 총정리
댓글